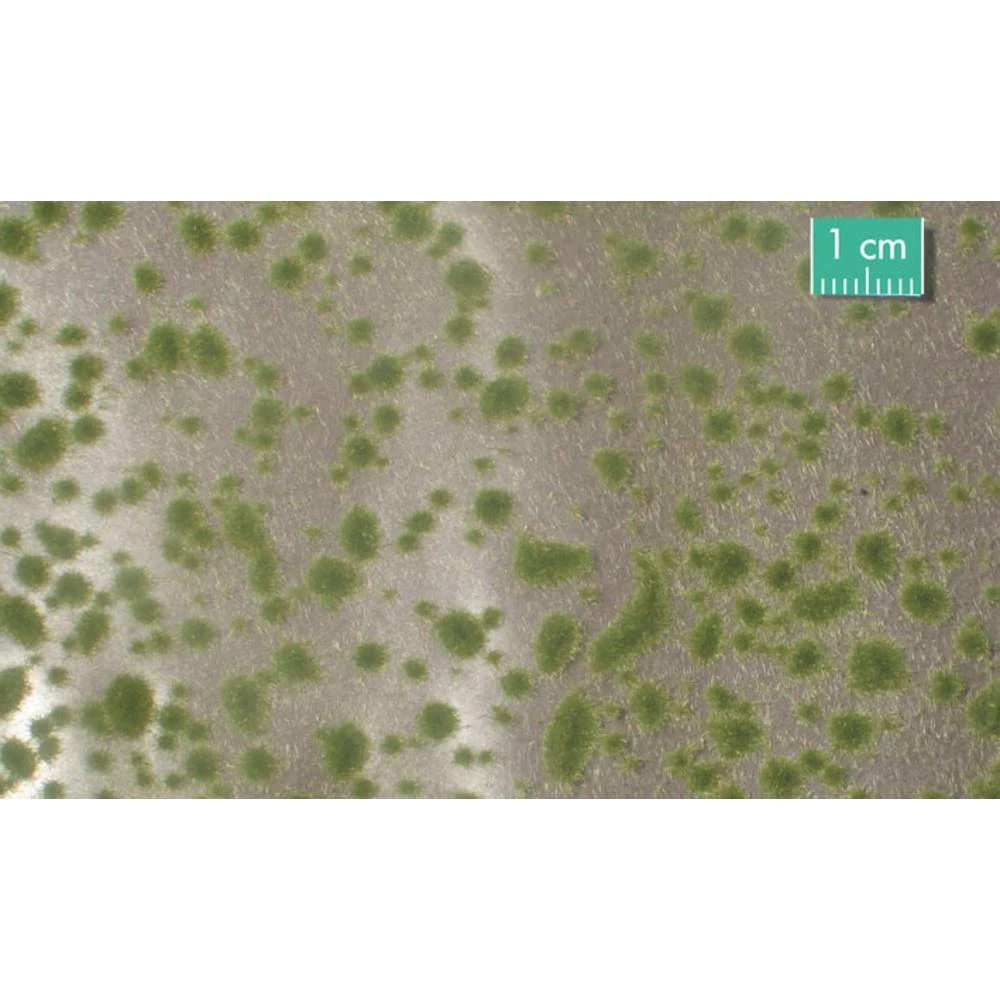

Mahovina Mininatur 747-23 S Početak jeseni boja
- Kataloški br:
- 1858369 - 62
- Oznaka:
- 747-23 S
- EAN:
- 4048847647237
- Kataloški br:
- 1858369 - 62
- Oznaka:
- 747-23 S
- EAN:
- 4048847647237
Mahovina Mininatur 747-23 S Početak jeseni boja

0.00 KM
Komada
Alternativno dostupni proizvodi:
Prikaži alternativne proizvode
Komada

Izdvojeno & Detalji
- Prirodne boje
Tehničke specifikacije
Tehničke specifikacije
Boja proizvođača
rana jesen
Dim.
(D x Š) 150 mm x 40 mm
Dobna skupina
od 15 godina
Duljina
150 mm
Sadržaj
14 g
Širina
40 mm
Vrsta proizvoda
jastučić od mahovine
Opis
Opis
Ovaj tekst je strojno preveden.